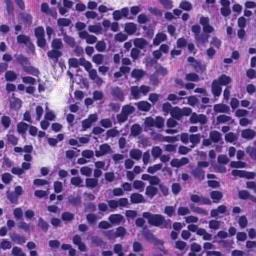
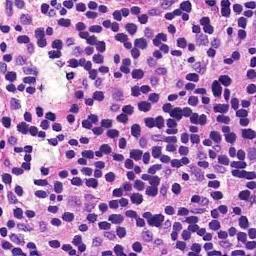
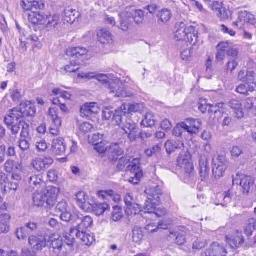
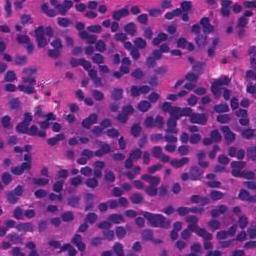
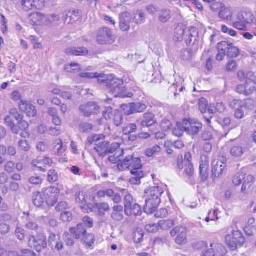
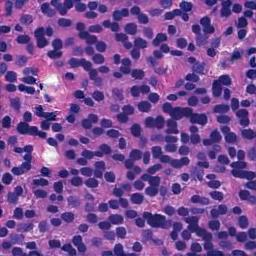
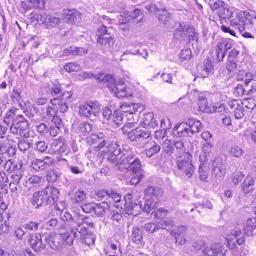
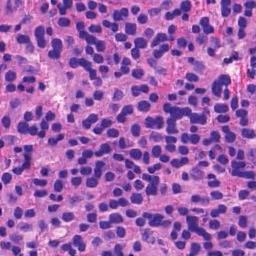
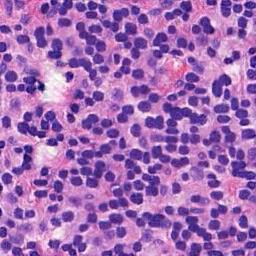

Automated synthesis of histology images has several potential applications in computational pathology. However, no existing method can generate realistic tissue images with a bespoke cellular layout or user-defined histology parameters. In this work, we propose a novel framework called SynCLay (Synthesis from Cellular Layouts) that can construct realistic and high-quality histology images from user-defined cellular layouts along with annotated cellular boundaries. Tissue image generation based on bespoke cellular layouts through the proposed framework allows users to generate different histological patterns from arbitrary topological arrangement of different types of cells. SynCLay generated synthetic images can be helpful in studying the role of different types of cells present in the tumor microenvironmet. Additionally, they can assist in balancing the distribution of cellular counts in tissue images for designing accurate cellular composition predictors by minimizing the effects of data imbalance. We train SynCLay in an adversarial manner and integrate a nuclear segmentation and classification model in its training to refine nuclear structures and generate nuclear masks in conjunction with synthetic images. During inference, we combine the model with another parametric model for generating colon images and associated cellular counts as annotations given the grade of differentiation and cell densities of different cells. We assess the generated images quantitatively and report on feedback from trained pathologists who assigned realism scores to a set of images generated by the framework. The average realism score across all pathologists for synthetic images was as high as that for the real images. We also show that augmenting limited real data with the synthetic data generated by our framework can significantly boost prediction performance of the cellular composition prediction task.
翻译:在计算病理学中,对组织图象的自动合成具有多种潜在应用。然而,现有的任何方法都无法产生现实的组织图象,带有明确的细胞布局或用户定义的生理学参数。在这项工作中,我们提议了一个名为SynClay(来自细胞布局的合成)的新框架,这个框架能够从用户定义的细胞布局以及附加注释的细胞界限中构建现实和高质量的组织图象。通过拟议框架的简单细胞布局,组织图象的生成使用户能够产生来自不同类型细胞任意的表面布局的不同合成图象形态。SynClay生成的合成图象可以有助于研究肿瘤微病毒中存在的不同类型细胞的构成作用。此外,它们可以帮助平衡组织图象中的细胞计数分布,以便通过尽量减少数据不平衡的影响来设计准确的细胞结构图象。我们以对抗性格和分类模型来完善核结构结构,并结合合成图象框架生成核面具。在推断过程中,我们将模型与另一个合成图理模型模型结合起来,用来生成结结结点图像的合成图象构成真实的合成图象结构图象结构图象组成。我们通过分析的深度的深度分析,我们所测定的模型的模型的图表分析,用来显示的进度图象分析,用来评估了真实的进度图象的进度图象学的进度图象,我们所判的进度图象,用来评估了所有测路路路路路路路段的进度图。